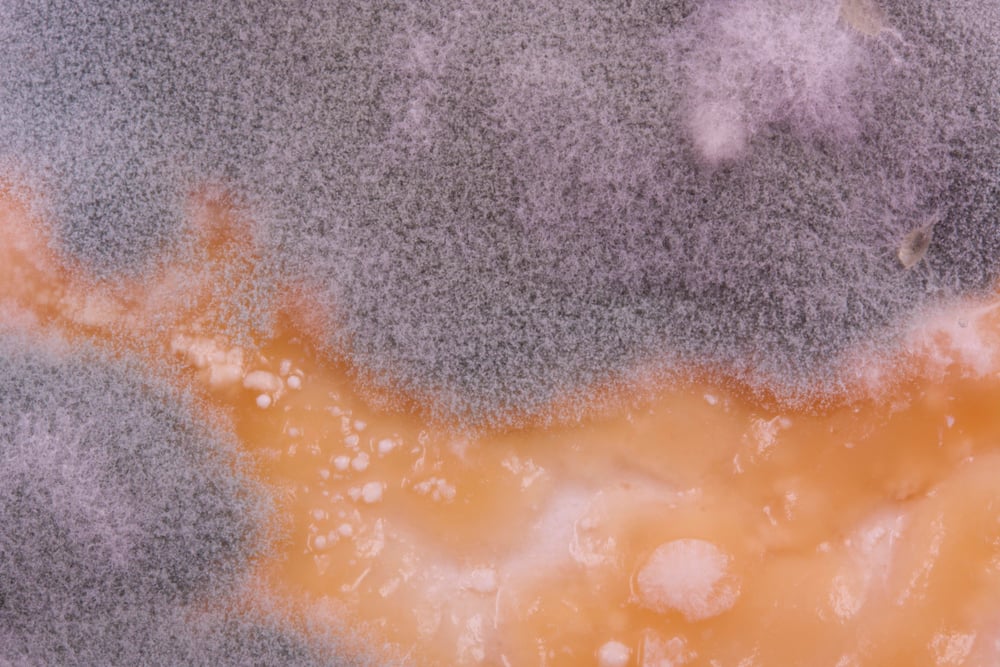

15 Overheard Conversations That Ended Up in the History Books
History often pivots on grand speeches and carefully planned declarations. Yet sometimes, it’s those casual words never meant for public ears that end up changing everything. These accidental eavesdropping moments have altered political landscapes, sparked world-changing innovations, and even prevented catastrophic disasters.
Here is a list of 15 overheard conversations that unexpectedly shaped our world in ways their speakers never imagined.
Alexander Graham Bell’s First Phone Call

Alexander Graham Bell was tinkering with his experimental telephone in 1876 when he accidentally spilled acid on himself. His frustrated exclamation – ‘Mr. Watson, come here, I want to see you’ – traveled through wire to his assistant working in another room.
Though merely a request for help, these mundane words became the first documented telephone conversation in history, proving Bell’s radical theory that human voice could indeed be transmitted electronically.
The Zimmermann Telegram

British intelligence officers in 1917 quietly intercepted a private telegram from German Foreign Minister Arthur Zimmermann to Mexico. The secret message proposed a military alliance against America, boldly offering to help Mexico reclaim territories in Texas, Arizona, and New Mexico.
When published in American newspapers, this intercepted communication sparked nationwide outrage and helped push the previously reluctant nation headfirst into World War I.
Nixon’s Oval Office Recordings

Richard Nixon’s paranoid habit of secretly recording White House conversations became his undoing during the Watergate scandal. The notorious “smoking gun” tape caught Nixon discussing ways to use the CIA to obstruct the FBI’s investigation – words he never dreamed would reach public ears.
These private conversations, captured on Nixon’s own recording system, ultimately forced the only presidential resignation in U.S. history.
The Space Shuttle Challenger Decision

Engineers at Morton Thiokol frantically argued against launching the Space Shuttle Challenger in cold weather back in 1986 – they’d noticed concerning O-ring failures in previous cold-weather launches. During a heated teleconference, a manager was overheard telling engineers to “take off your engineering hat and put on your management hat” – essentially demanding they prioritize schedule over safety concerns.
This conversation, later exposed during congressional hearings, revealed the fatal organizational pressure that contributed to the tragic explosion.
The Manhattan Project Leak

A seemingly innocent conversation at a Washington DC cocktail party between journalist Shelby Scates and a government official inadvertently revealed classified information. The tipsy official casually mentioned “unusual power consumption” for a small Tennessee town called Oak Ridge.
He didn’t realize he’d just leaked crucial details about uranium enrichment facilities for atomic bombs. This overheard chat provided one of the first public hints about the top-secret Manhattan Project.
Leonardo da Vinci’s Shopping List

Historians couldn’t believe their luck when they discovered a 15th-century grocery list written by Leonardo da Vinci. The ordinary note listed common items – herring, wine, bread – while the margins contained extraordinary sketches of flying machines and engineering concepts.
This accidentally preserved document offers a remarkable glimpse into both everyday Renaissance life and how da Vinci’s brilliant mind constantly worked on innovations even during the most routine tasks.
The Origin of Coca-Cola’s Secret Formula

Pharmacist John Pemberton was discussing his new medicinal syrup with a colleague at Jacobs’ Pharmacy in Atlanta – they weren’t aware a customer was listening nearby. This eavesdropper chimed in with a suggestion: “Why not mix it with carbonated water instead of flat?”
Though merely a passing comment, this overheard suggestion in 1886 contributed to creating what would become Coca-Cola – today one of the world’s most recognized brands.
The Watergate Break-In Discovery

During his rounds at the Watergate complex, security guard Frank Wills may have overlooked the taped door locks as ordinary maintenance activity. Around midnight, though, soft murmurs from within the structure drew his notice—sounds that ought not to have existed.
These overheard whispers drove him to contact the police, who found thieves putting listening devices in the Democratic National Committee offices, so starting the controversy that would topple a presidency.
Alexander Fleming’s Mold Discovery
Alexander Fleming was complaining to a colleague at his 1928 lab about a tainted petri dish that had destroyed his staphylococci cultures. His watchful colleague looked at the dish and saw something odd: bacteria would not grow anywhere close to the unknown mold.
Fleming’s complaints prompted this informal remark, which later led him to look more closely to discover penicillin, transforming medicine all around the world.
The Berlin Wall’s Accidental Opening

East German official Günter Schabowski hadn’t fully read the new travel regulation changes before his November 1989 press conference. When questioned about implementation timing, journalists overheard him mumble that the regulations would take effect “immediately” rather than the planned next day.
This misstatement – broadcast live across East Germany – prompted thousands to flood border checkpoints that very night, essentially forcing the opening of the Berlin Wall through a communication error.
The Cuban Missile Crisis Backchannel

During the terrifying peak of the Cuban Missile Crisis, ABC correspondent John Scali happened to eat lunch next to a Soviet embassy official at a Washington restaurant. Scali overheard the Russian discussing potential peaceful resolutions to the standoff.
This chance encounter established a crucial unofficial communication channel between Soviet and American leaders that helped prevent nuclear war, giving both sides a way to negotiate without losing face publicly.
The Rosetta Stone Discovery

French soldier Pierre-François Bouchard was leading construction on a fort near Rosetta, Egypt in 1799 when he overheard local workers discussing strange markings on a black stone they’d uncovered. Following this conversation, Bouchard examined the stone himself and recognized its potential importance.
This accidental discovery provided the key that scholars needed to finally decipher Egyptian hieroglyphics after 1,400 years of mystery.
Einstein’s Lost Equation

A Princeton University cleaning staff member noticed Albert Einstein muttering equations to himself late one night in 1935. Though she couldn’t understand the mathematics, she jotted down the strange symbols on scrap paper.
Einstein later found this note and reportedly exclaimed that it contained a solution he’d been struggling to complete. This chance recording preserved an important calculation that might otherwise have vanished from scientific history.
The Discovery of Velcro

Swiss engineer George de Mestral returned from a 1941 hunting trip and complained loudly about the annoying burrs stuck to his clothes and dog. A visitor listening to his frustration suggested examining the troublesome burrs under a microscope.
This microscopic view revealed the tiny hooks that inspired Mestral to create what became Velcro, transforming fastener technology for everything from children’s shoes to sophisticated spacecraft components.
The Pentagon Papers Leak

RAND Corporation analyst Daniel Ellsberg expressed his growing concerns about Vietnam War deceptions during a private conversation with colleague Anthony Russo in 1971. This discussion prompted Russo to suggest Ellsberg take concrete action with his insider knowledge.
The resulting leak of classified documents known as the Pentagon Papers revealed systematic government deception about the war’s progress, fundamentally shifting public opinion and political calculations about American involvement in Southeast Asia.
Echoes Through Time

These accidental eavesdropping moments reveal how history often unfolds through unplanned circumstances and unintended audiences. From world-changing inventions to political scandals that toppled governments, these overheard words demonstrate the sometimes razor-thin boundary between private conversation and public consequence.
Every casual remark carries potential energy—the next offhand comment someone overhears might just alter human history, whether its speaker realizes it or not.
More from Go2Tutors!

- The Romanov Crown Jewels and Their Tragic Fate
- 13 Historical Mysteries That Science Still Can’t Solve
- Famous Hoaxes That Fooled the World for Years
- 15 Child Stars with Tragic Adult Lives
- 16 Famous Jewelry Pieces in History
Like Go2Tutors’s content? Follow us on MSN.